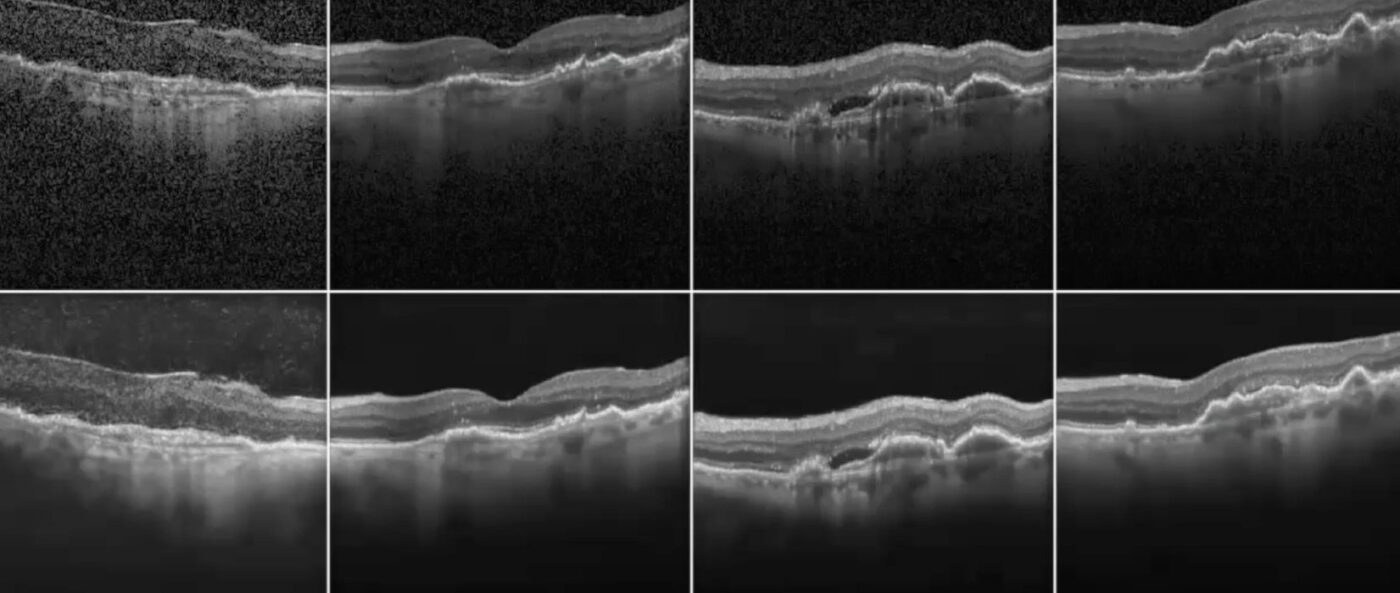

Por favor Acceso para ver el contenido.(¿No eres miembro? ¡Únete hoy!)
Archivos de Categoría: Trabajo de Ingreso
Por favor Acceso para ver el contenido.(¿No eres miembro? ¡Únete hoy!)
Por favor Acceso para ver el contenido.(¿No eres miembro? ¡Únete hoy!)
Por favor Acceso para ver el contenido.(¿No eres miembro? ¡Únete hoy!)
Por favor Acceso para ver el contenido.(¿No eres miembro? ¡Únete hoy!)